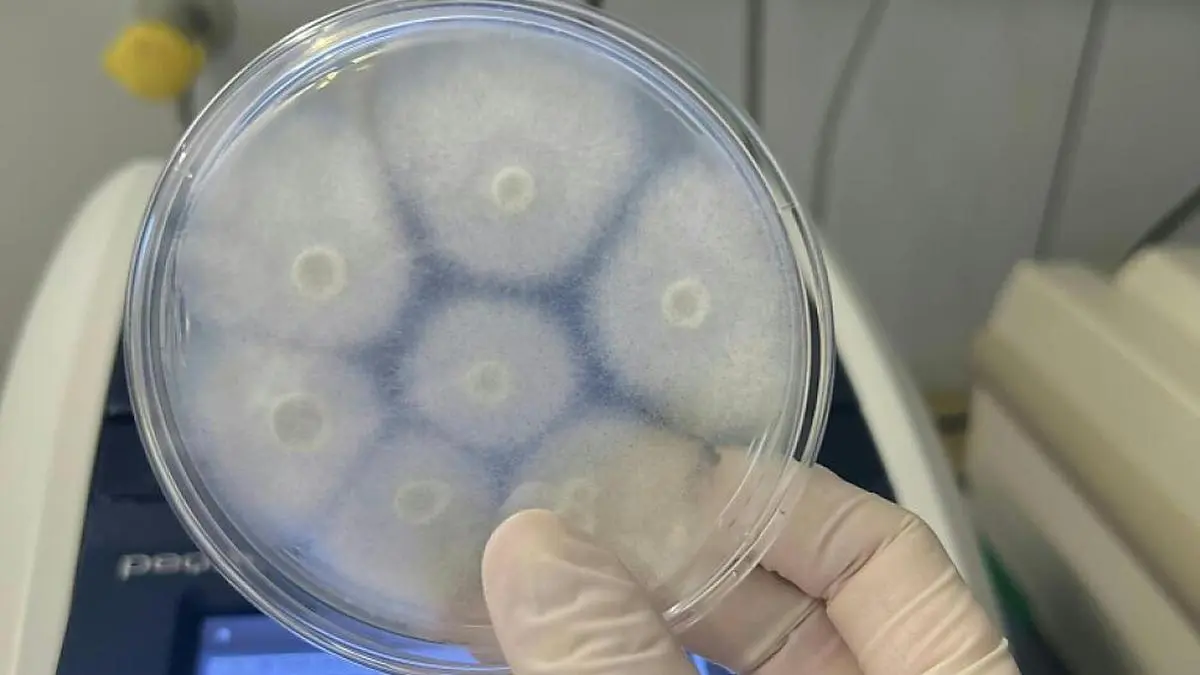

Innsbruck
Diagnose-Verbesserung bei schwerer Pilzerkrankung erwartbar
Eine Diagnose-Verbesserung bei der schweren Pilzerkrankung Mukormykose ist in Sicht. Eine große Forschungsarbeit - Wissenschafter der Medizinischen Universität Innsbruck waren dabei federführend - belegt die Leistungsfähigkeit von PCR-Tests für die Erkennung der seltenen Krankheit. Damit werde eine Grundlage für "frühe, gezielte Therapien" und letztlich zur "Verringerung der Sterblichkeit" geschaffen, sagte Mykologin Michaela Lackner von der Med-Uni Innsbruck im APA-Gespräch.
© MEDUNI INNSBRUCK